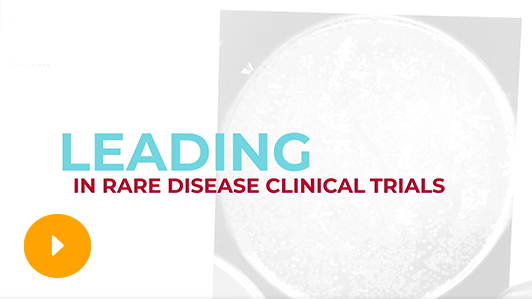
Text "Leading in rare Disease Clinical Trials"

Part of Alexion’s commitment to bringing together stakeholders in the rare disease community to listen to and learn from each other.
LET’S DISCUSS THE INFLATION REDUCTION ACT
Watch the replay of Alexion’s Listening & Learning webinar on the IRA’s implications for rare disease patients as well as the Midterm election results and what they mean for the IRA.
We also encourage you to read this whitepaper to learn how the Orphan Drug Act sparked progress for rare disease treatments.